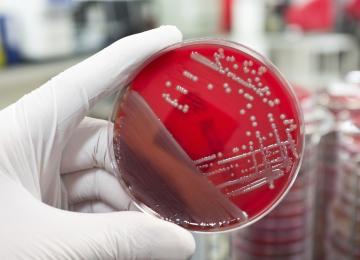

As Paris tourism struggles to overcome last November’s Islamist attacks, the world’s most visited city faces a new threat: a wave of protests and further planned strikes, tourism officials warned…
People
<p>Iran people news, Read the latest news on Iran's society, including developments in sciences, education, universities, and students, along with stories about Iran health sector. </p>
- People
A new study suggests that the link between a person’s health and the quality of their marriage may be less straightforward than we might assume.
PeopleThe Health Ministry held 130,000 workshops and educational sessions on Malta fever (Brucellosis) in the past year that ended in March for 1.8 million people across the country.
PeopleRepresentatives from Iran will join delegations from 186 countries at the 105th session of the International Labor Conference (May 30-June 10) in Geneva.
PeopleIran’s Integrated System of Vehicle Inspection has enabled the police to identify vehicles that lack inspection documents and drivers who carry fake certificates, by providing quick access to…
PeopleOver the past two years and in the last couple of months in particular, 700 parents have been summoned to court on charges of absenteeism of their children from school, said Deputy Education…
PeopleThe International Day of Families is observed globally on May 15 every year. Proclaimed by the UN General Assembly in 1993, the occasion reflects the importance attached to families by the…
PeopleWhile the number of drug addicts in the country is often put at 1.3 million by the Iran Drug Control Headquarters, it should be revised “as it is way above this figure,” and likely around 2…
PeopleThe opening ceremony for the National No Tobacco Week was held at the Ministry of Health in Tehran on Monday and attended by senior health officials.
PeopleNorwegian universities have called off a discriminatory ban that did not allow Iranian students to study in the European country, following the implementation of the nuclear deal and lifting of…
PeopleAnimal rights activists are reacting strongly on social media after a gorilla was killed at a zoo in Cincinnati, USA on Saturday.
The 17-year-old male gorilla named Harambe was shot by a…
PeopleAt least 35% of corals in the northern and central parts of Australia’s Great Barrier Reef have been destroyed by bleaching, Australian scientists say.
The experts from James Cook…
PeopleThe office of the governor of Neka in Mazandaran Province has issued a statement denying claims that a new road will be constructed in Paband National Park.
The media picked up on a report…
PeopleThe salinity of the Persian Gulf has been increasing for the past two decades, and is now 1.5 times as saline as it was 20 years ago, according to Parvin Farshchi, deputy for marine environment at…
PeopleThe law has been left unenforced for so long that brazen contractors see no need to comply with orders issued by authorities; case in point being the construction of Sabzkouh Water Supply Tunnel…
PeopleThe size of an average Iranian family seems to have become smaller in the recent decades and Health Ministry officials warn that Iran’s population growth rate is expected to enter negative…
PeopleMayor of Vienna Michael Haupl discussed areas for bilateral cooperation with Tehran Mayor Mohammad-Bagher Ghalibaf, in a meeting on Sunday that included plans “to improve the quality of life in…
PeopleTop 30 participants in the 26th National Handicraft Exhibition will be sent to international handicraft events by Iran’s Cultural Heritage, Handicrafts and Tourism Organization as representatives…
PeopleTurkey experienced its biggest drop in foreign tourist arrivals on record last month, as tensions with Russia and a series of deadly bombings kept visitors away from the country’s beaches.
PeopleThree more of Thailand’s most stunning islands are being shut down as a result of what the local media call “excessive tourism.”
The Thai government, in an effort to save the idyllic white…
PeopleTourism professionals in Gilan Province want to take advantage of the province’s vast expanse of natural landscapes to boost tourism and the local economy. As such, there are plans to establish a…
PeopleThe Iranian Hoteliers Society has responded officially to the demolition of the illegal construction of additional floors of a hotel building in Shiraz, Fars Province.
According to Mehr…
PeopleAbout 10 years ago, the world’s fourth successful transplant of stem cells for treatment of ‘aplastic anemia’ was conducted in Iran, Isfahan Province on a 7-year-old boy, Karen Shivaee. “Karen has…
PeopleAround 15,000 jobs have been created so far in the remote and underprivileged areas of Kurdistan Province by the Barakat Foundation since its establishment in 2008. The jobs were created directly…
PeopleUS health officials have reported the first case in the country of a patient with an infection resistant to a last-resort antibiotic, and expressed grave concern that the superbug could pose…
People